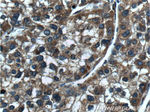
PARVA Antibody in Immunohistochemistry (Paraffin) (IHC (P))

Search
Proteintech
PARVA Polyclonal Antibody
{{$productOrderCtrl.translations['antibody.pdp.commerceCard.promotion.promotions']}}
{{$productOrderCtrl.translations['antibody.pdp.commerceCard.promotion.viewpromo']}}
{{$productOrderCtrl.translations['antibody.pdp.commerceCard.promotion.promocode']}}: {{promo.promoCode}} {{promo.promoTitle}} {{promo.promoDescription}}. {{$productOrderCtrl.translations['antibody.pdp.commerceCard.promotion.learnmore']}}
产品信息
55268-1-AP
种属反应
已发表种属
宿主/亚型
分类
类型
抗原
偶联物
形式
浓度
规格
纯化类型
保存液
内含物
保存条件
运输条件
产品详细信息
This antibody is specific to PARVA.
靶标信息
The protein encoded by this gene is a transcription factor that contains C2H2-type zinc-fingers. It also contains a positive regulatory domain, which has been found in several other zinc-finger transcription factors including those involved in B cell differentiation and tumor suppression. Studies of the mouse counterpart suggest that this protein may be involved in the development of the central nerve system (CNS), as well as in the pathogenesis of neuronal storage disease. Multiple alternatively spliced transcript variants encoding distinct isoforms have been observed.
仅用于科研。不用于诊断过程。未经明确授权不得转售。
生物信息学
蛋白别名: Actopaxin; Alpha-parvin; Calponin-like integrin-linked kinase-binding protein; CH-ILKBP; FLJ10793; FLJ12254; Matrix-remodeling-associated protein 2; unnamed protein product
基因别名: 2010012A22Rik; 5430400F08Rik; Actp; AI225929; AU042898; CH-ILKBP; MNCb-0301; MXRA2; PARVA; Parvin
UniProt ID: (Human) Q9NVD7, (Rat) Q9HB97, (Mouse) Q9EPC1
Entrez Gene ID: (Dog) 476859, (Human) 55742, (Rat) 57341, (Mouse) 57342